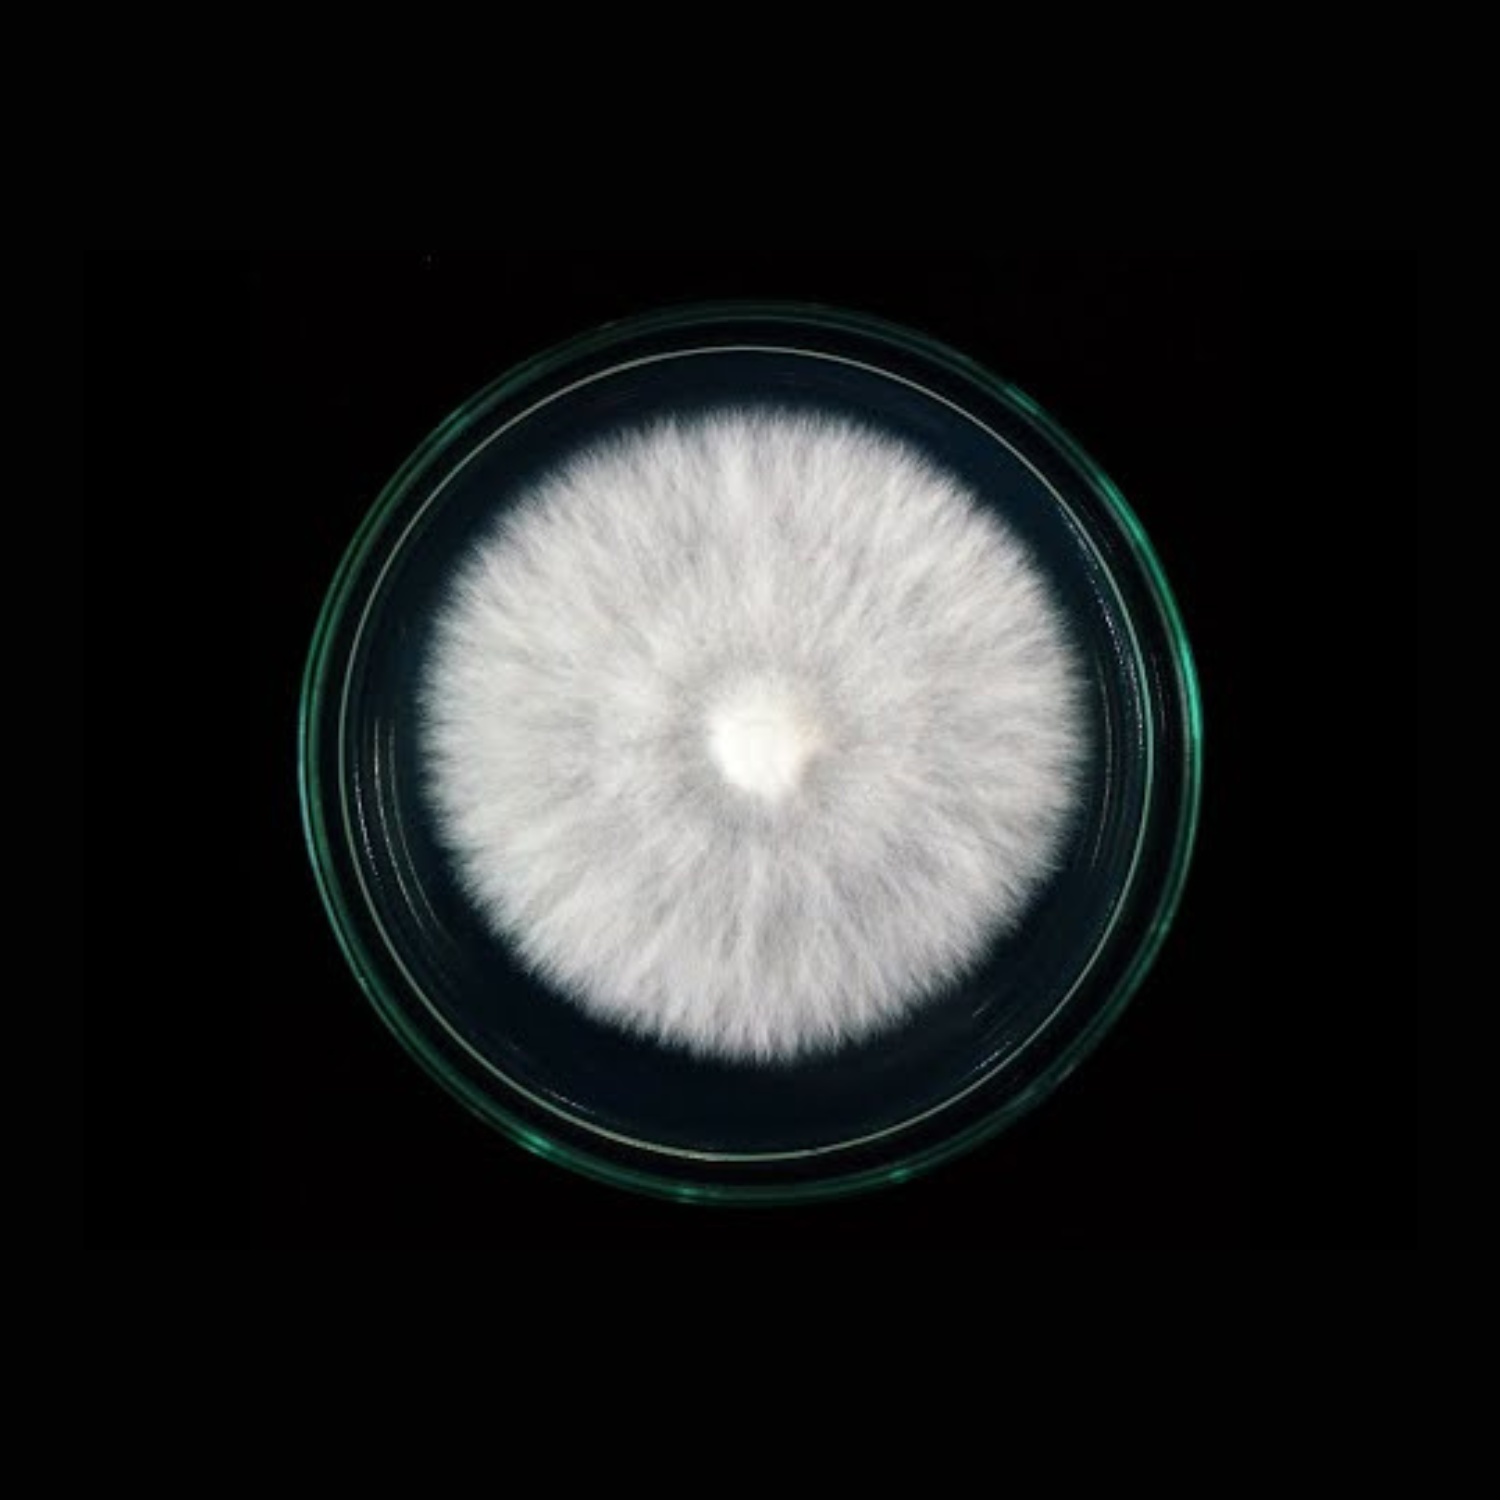
fully colonized agar plate

Cordyceps militaris is one of the most studied medicinal mushrooms, valued for its potent levels of cordycepin and adenosine—bioactive compounds with antioxidant, anti-inflammatory, and neuroprotective benefits. This culture offers a reliable entry point into functional mushroom production, nootropic formulation, or genetic research.
Our plates are produced under sterile conditions using nutrient-rich agar and verified for sector-free, contamination-free mycelial growth. This strain performs consistently across multiple substrates and maintains high cordycepin output under controlled conditions.
What You’ll Receive
- 1 × 100 mm agar plate fully colonised with C. militaris mycelium
- Clear strain ID and pour date for tracking
- Freshly prepared 5–7 days before dispatch
- Viability best within 4 weeks (store at 2–5 °C)
Growth Conditions
- Colonisation: 22–25 °C in low light, 60–70% humidity
- Fruiting: 15–20 °C, 12–14 hours of LED light (~1000 lux), 85–90% humidity, light fresh-air exchange
- Preferred substrate: Sterilised brown rice or whole grain mix, optionally enriched with soy or insect meal for higher cordycepin yields
Applications
- Expand into grain spawn for fruiting or liquid culture development
- Use for lab research, bioactive compound extraction, or supplement prototyping
- Maintain in culture libraries for long-term storage or genetic isolation
Why choose this culture? Cordyceps militaris is gaining global attention for its adaptogenic and performance-enhancing properties. This plate gives you a clean, research-grade foundation for growing a species that’s as respected in science as it is in traditional medicine.

Reviews
There are no reviews yet.